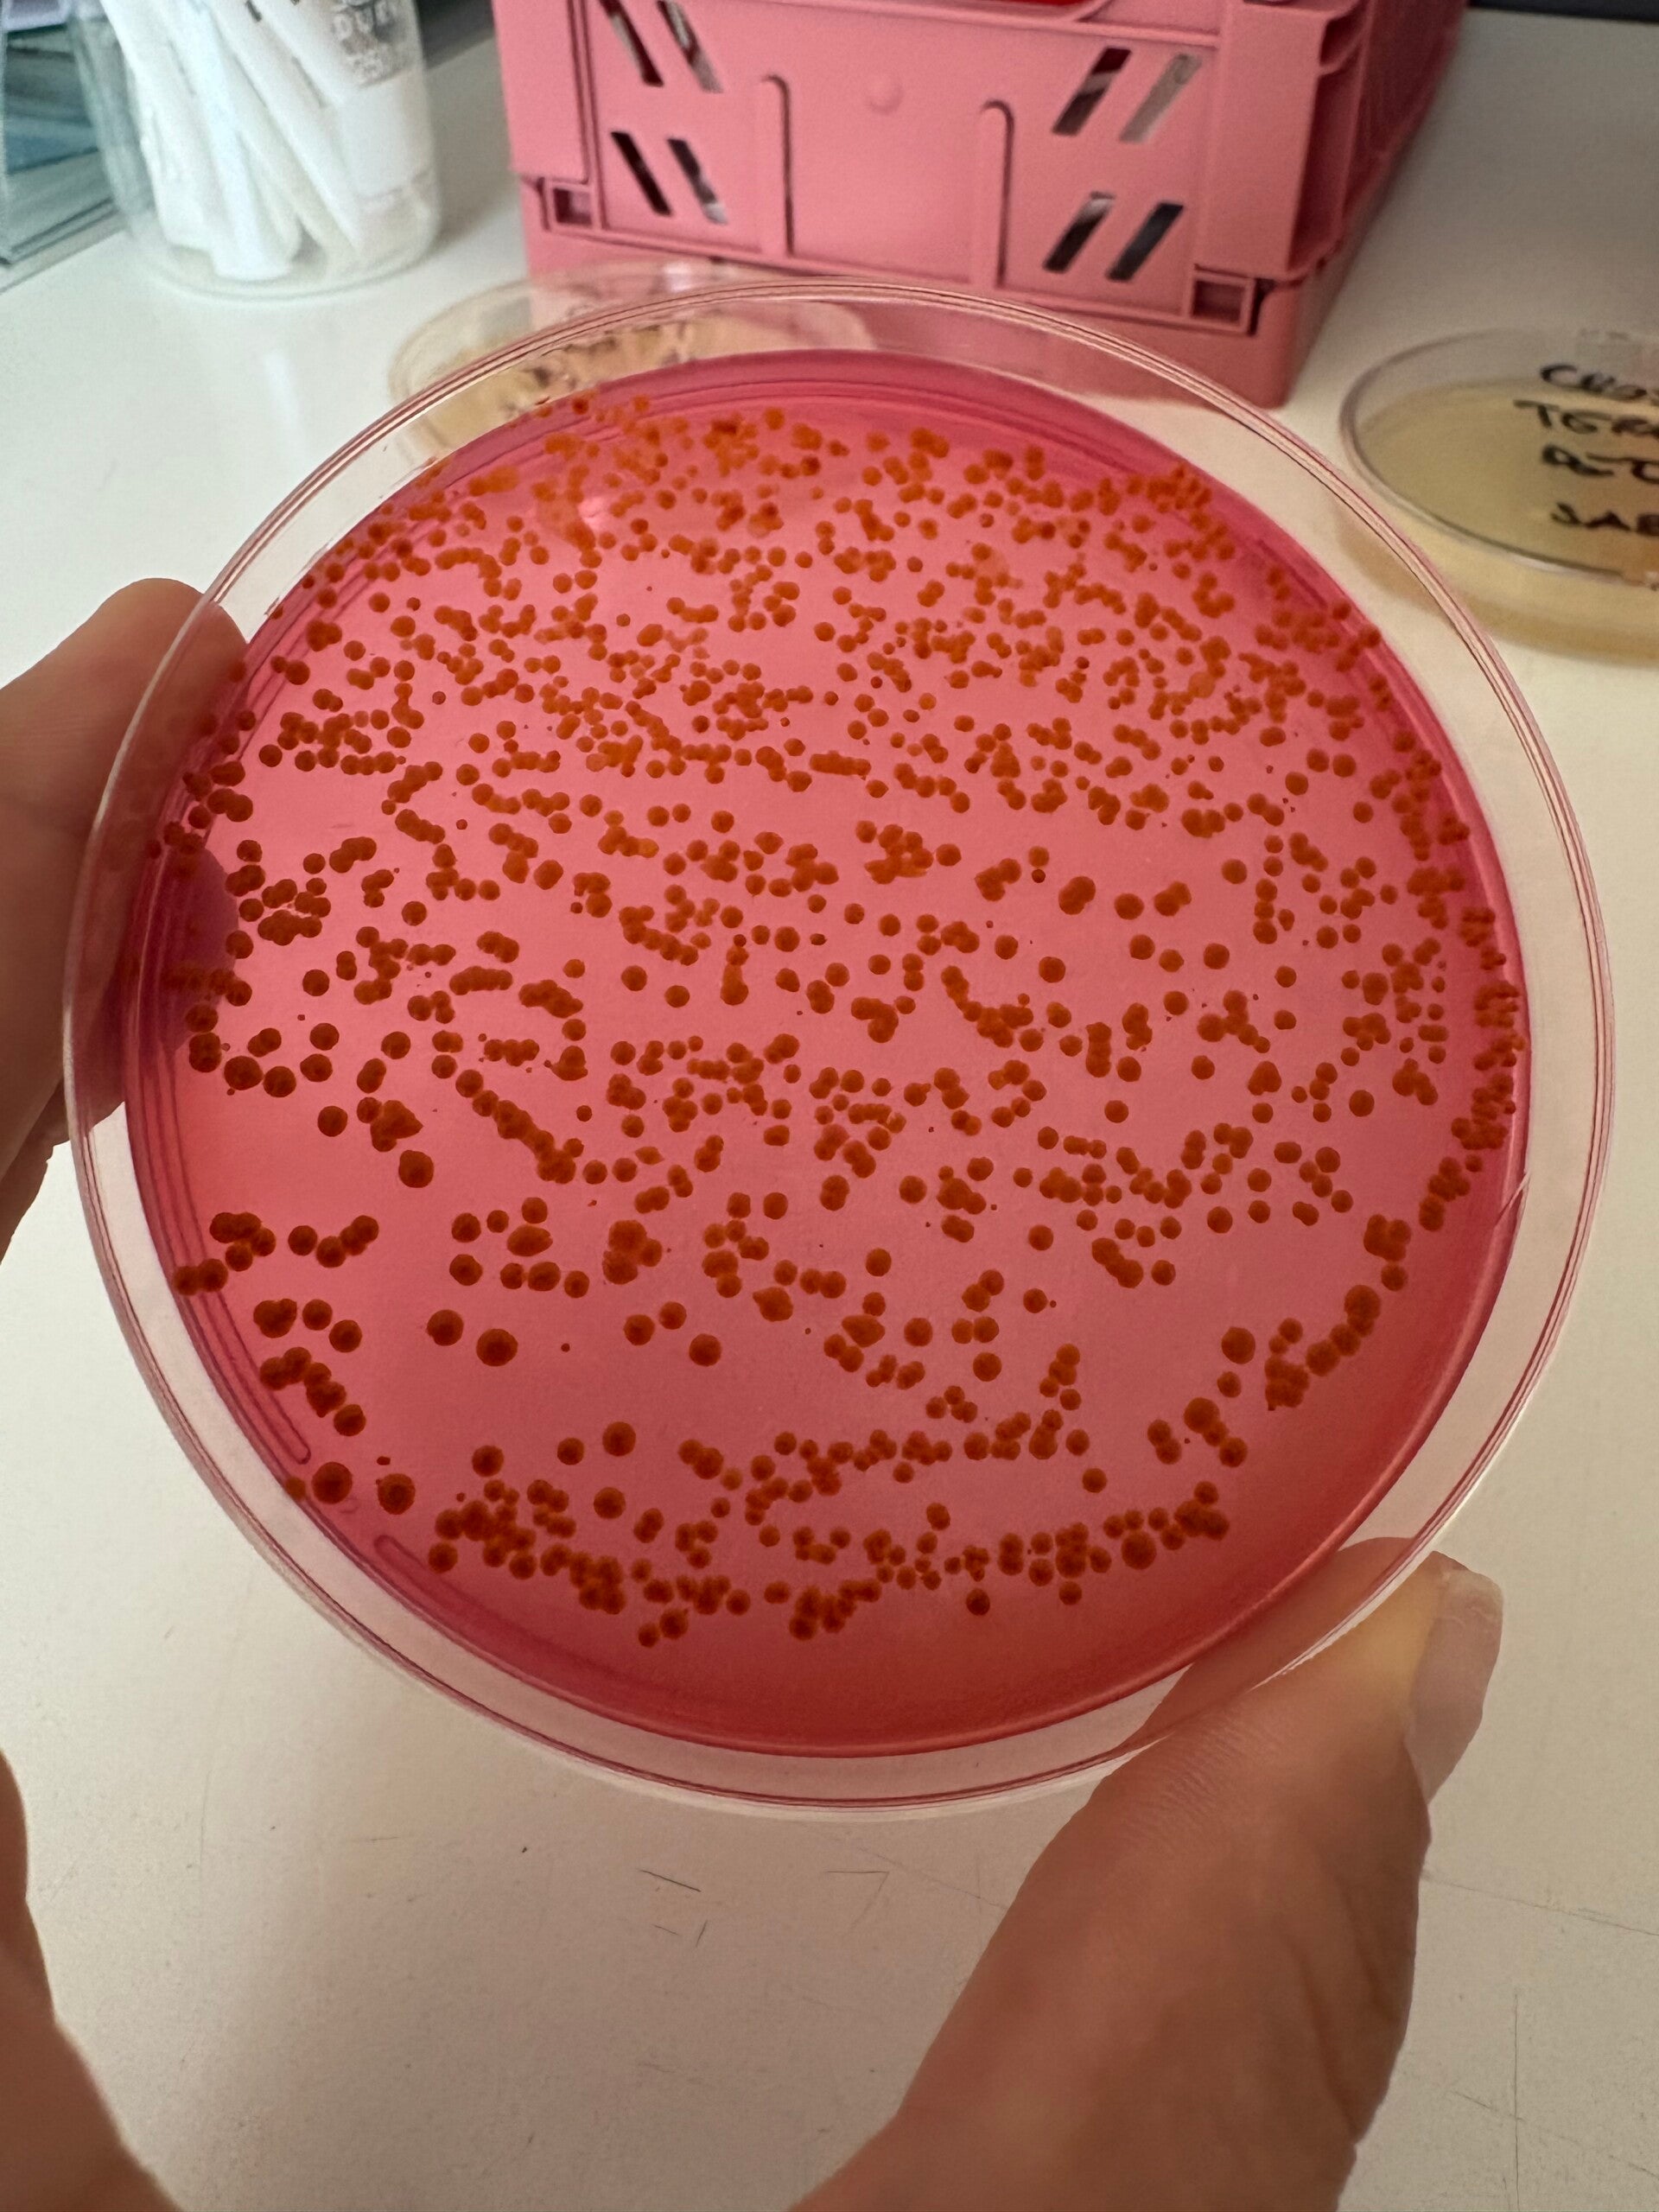

LABORATORIO LV
Benvenuti nel nostro Laboratorio Analisi Microbiologiche Agroalimentari, un punto di riferimento per la sicurezza e la qualità nel settore agroalimentare. La nostra missione è garantire che i prodotti alimentari siano sicuri, genuini e conformi agli standard più elevati. Attraverso analisi microbiologiche precise e affidabili, supportiamo aziende, produttori e professionisti del settore nel controllo e nel monitoraggio della qualità dei loro prodotti. Il nostro impegno per offrire qualità e un ottimo servizio è al centro di tutto ciò che facciamo. Unisciti a noi per crescere insieme e raggiungere il successo. Siamo felici di accoglierti e di essere parte della tua storia nel mondo agroalimentare!
COSA ANALIZZIAMO PER TE
Offriamo un servizio di analisi microbiologiche completo per la tua azienda Agroalimentare . e non solo !
Viene fornito un rapporto di Prova conferme alla normativa , in formato pdf con riferimenti e limiti che possono aiutarti a capire il risultato e se hai difficoltà non esitare a contattarci .
Tamponi di superficie
Tamponi di superficie e su strumentazione , indicati sul tuo piano , un esame rapido con una risposta chiara in riferimento a tutta la normativa vigente in materia di igiene alimentare.
Alimenti e acque
Analizziamo tutte le materie prime e il prodotto finito , con riferimenti al Codex e alle norme vigenti .
analizziamo anche acqua di rete , di pozzo e di piscina
Cosmetici
Analizziamo cosmetici per la tua produzione o come laboratorio conto terzi , challenge test , metalli pesanti , test di stabilità chimico-fisica e microbiologica.